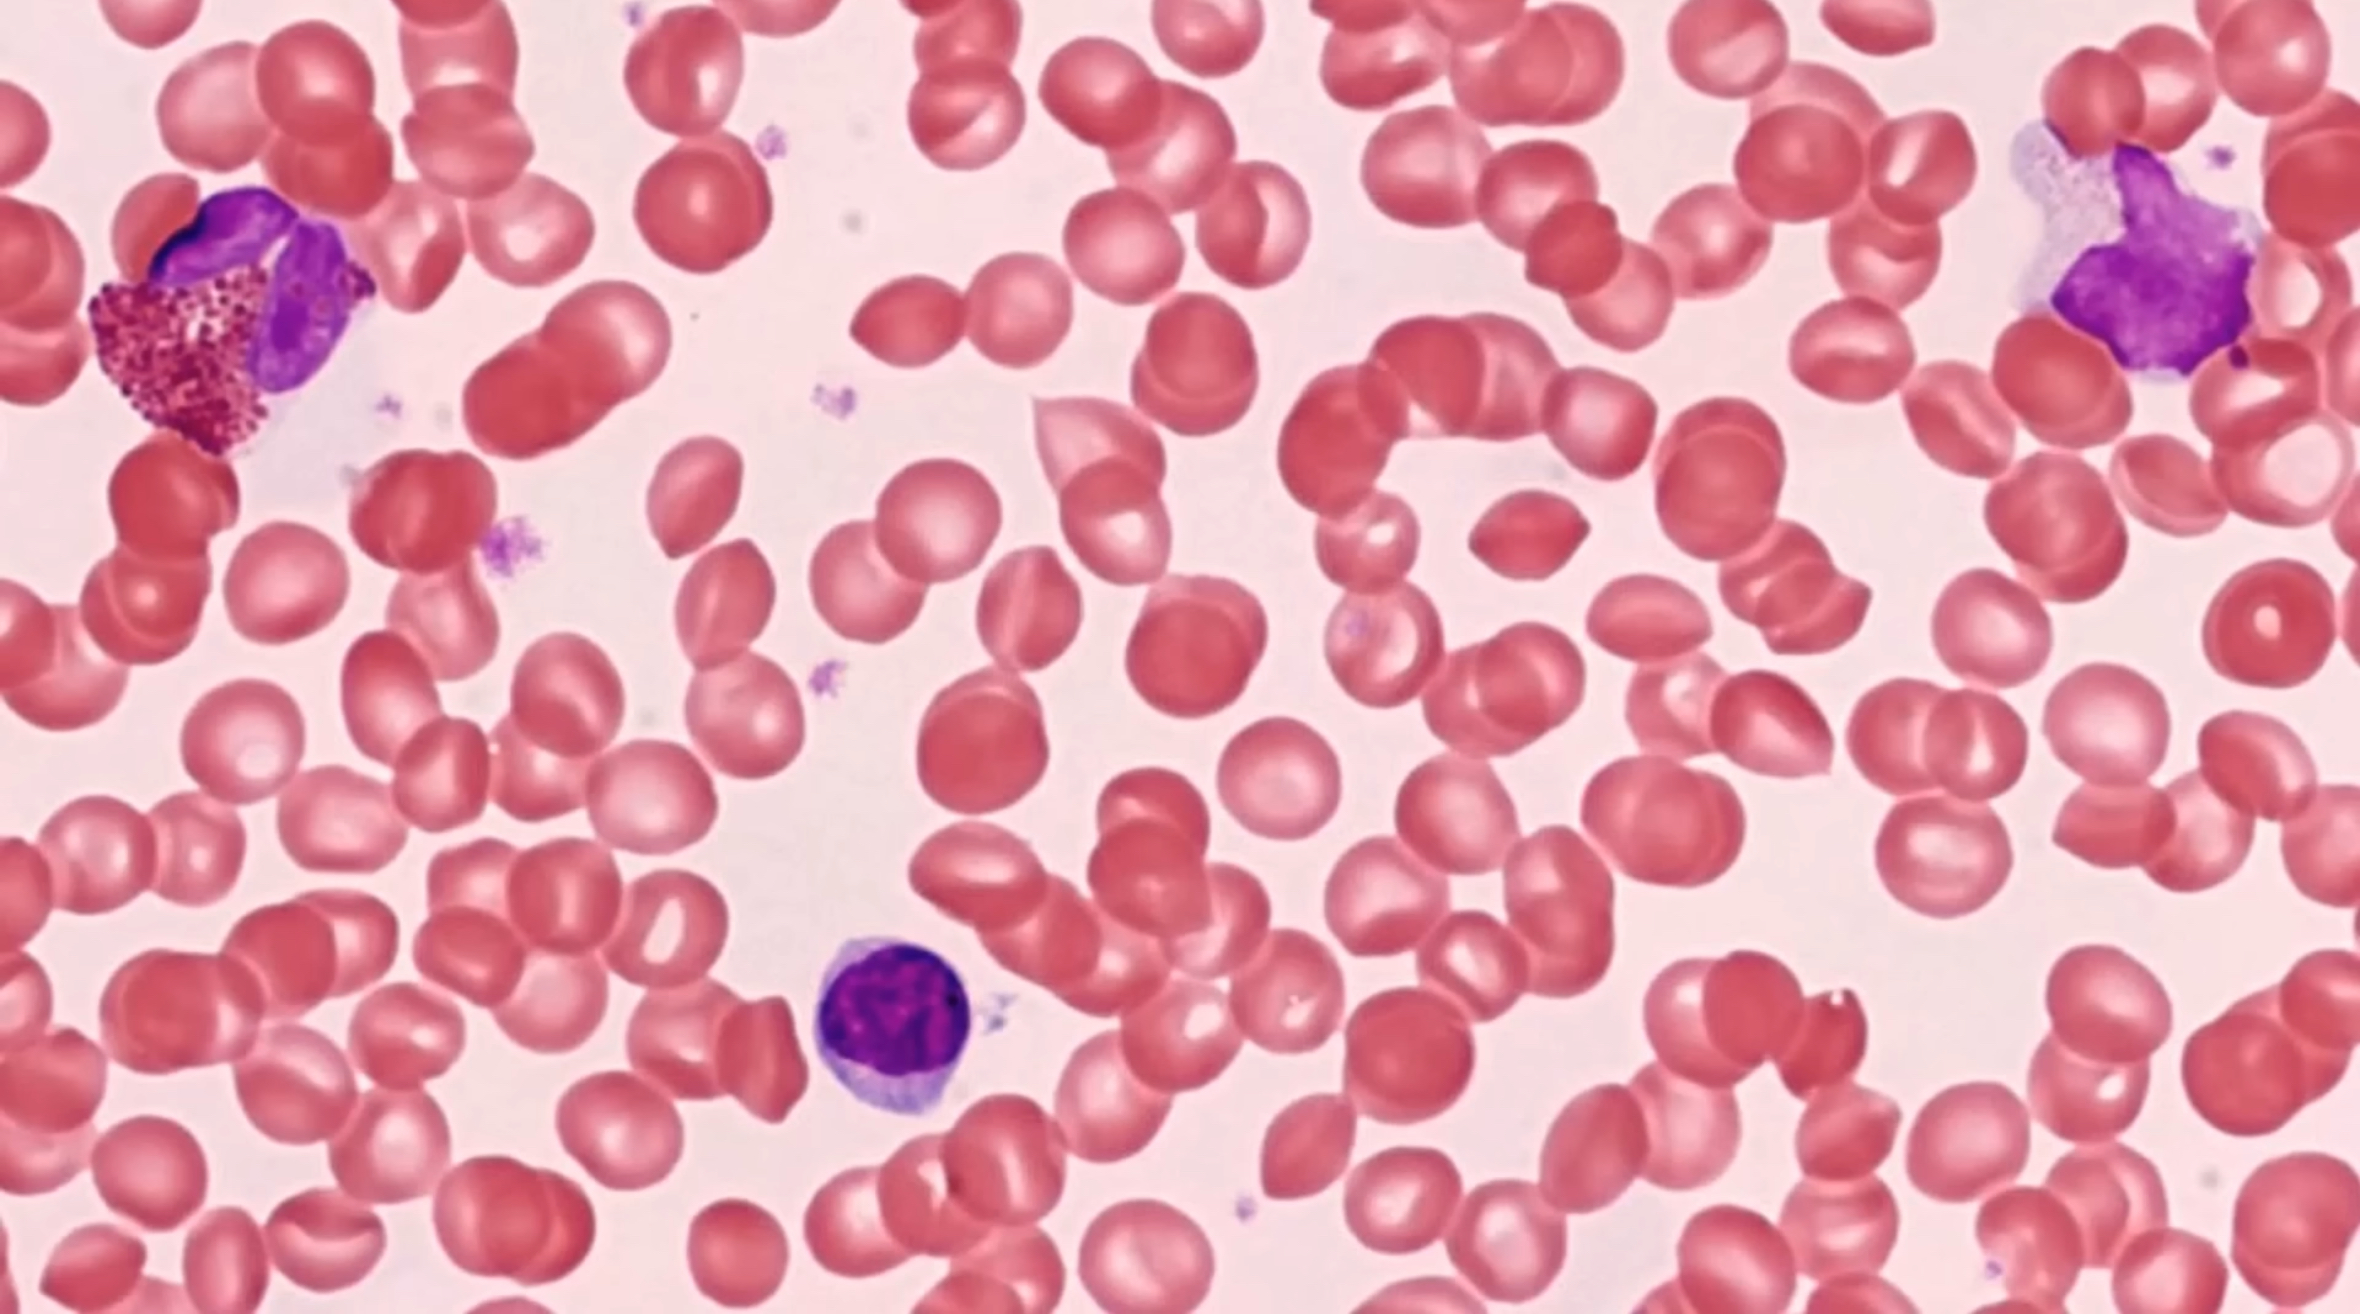

Histology
1/51
There's no tags or description
Looks like no tags are added yet.
Name | Mastery | Learn | Test | Matching | Spaced |
|---|
No study sessions yet.
52 Terms

Tissue: simple squamous epithelium
Location:
kidneys
alveoli
lining of heart, blood and lymphatic vessels
ventral body cavity lining
Function:
diffusion and filtration
secretes lubricating substance

wwswww

Tissue:
Location:
Function:

Tissue:
Location:
Function:

Tissue:
Location:
Function:

smaller duct
Tissue: simple cuboidal epithelium
Location: Pancrease
Function:
secretion and absorption

larger duct
Tissue: simple columnar epithelium
Location: pancreas
Function:
absorption, secretion of mucus enzymes and other subs
ciliated: propel mucus or reproductive cells by ciliary action







Tissue: pseudostratified columnar epithelium
Location: larynx
Function:
secretion of mucus
ciliated: propel mucus by ciliary action









Tissue: nonkeratinized stratified squamous epithelium
Location: anterior surface of cornea
Function:
protects underlying tissues in areas subject to ABRASION
surface is exposed to air and is non-keratinized, the epithelium must be kept constantly moist with tears.



Tissue: relaxed transitional epithelium
Location: Lower Urinary Tract
also in: ureters, urinary bladder, part of urethra
Function:
stretches and permits distention


Tissue: transitional epithelium
Location: bladder
also in: ureters, urinary bladder, part of urethra
Function:
stretches and permits distention



Tissue: Dense Regular Connective Tissue
Location: tendons and ligaments
Function:
tendon: muscle to bone
ligaments: muscle to muscle

Tissue: Dense Irregular Connective Tissue
Location: Dermis
Function:
strength and elasticity


Tissue: Dense Regular Connective Tissue
Location: tendons and ligaments
Function:
tendon: muscle to bone
ligaments: muscle to muscle


Tissue: Areolar Connective Tissue
Location:
under epithelia
packages organs
capillaries
Function:
wraps and cushions organs
holds tissue fluid
main battlefield against infection



hyaline cartilage
elastic cartilage
fibrocartilage

Tissue: Skeletal Muscle Tissue
Location:
skeletal muscles attached to bones
Function:
voluntary movement
manipulation of environment
facial expressions



